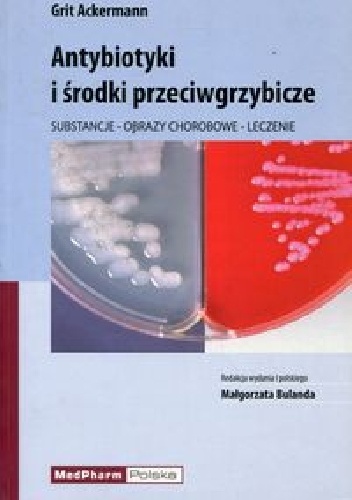
Antybiotyki i środki przeciwgrzybicze - Grit Ackermann

Antybiotyki i środki przeciwgrzybicze - Grit Ackermann
- Kategoria
- Dodał
-
- ebook
- pobierz
- mobi
- epub
Właściwe leczenie antybiotykami wymaga fachowej wiedzy i odpowiedniego doświadczenia, tak aby zastosowana terapia była skuteczna, niedroga i dobrze tolerowana przez pacjenta. Niniejsza książka obejmuje wiedzę z zakresu antybiotyków, leków przeciwgrzybiczych, jak i przeciwgruźliczych.
Aby uzyskać dostęp do całego serwisu zarejestruj się!
Rejestracja jest darmowa i bardzo szybka! Kliknij tutaj aby założyć konto. Trwa to tylko 15 sekund!.
Rejestracja jest darmowa i bardzo szybka! Kliknij tutaj aby założyć konto. Trwa to tylko 15 sekund!.
chomikuj, do pobrania pdf
